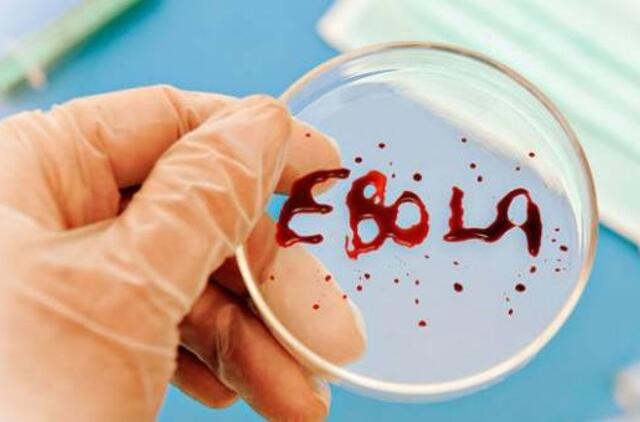
JAV dėl Ebolos griežtina kontrolę penkiuose šalies oro uostuose

Jungtinės Valstijos dėl Ebolos epidemijos griežtina iš Vakarų Afrikos atvykstančių asmenų kontrolę, praneša agentūra AFP.
Griežtesnė kontrolė galios Atlantos, Čikagos ir Vašingtono bei abiejuose Niujorko tarptautiniuose oro uostuose, trečiadienį paskelbė Baltieji rūmai.
Sveikatos tarnybos duomenims, be kita ko, bus tikrinama iš epidemijos apimtų šalių atvykstančių keleivių kūno temperatūra. Be to, jiems bus pateikti specialūs klausimai.
Naujos kontrolės priemonės bus pradėtos taikyti savaitgalį arba kitos savaitės pradžioje.
Šiuo metu mirtinas virusas siautėja Liberijoje, Siera Leonėje ir Gvinėjoje.

Rašyti komentarą